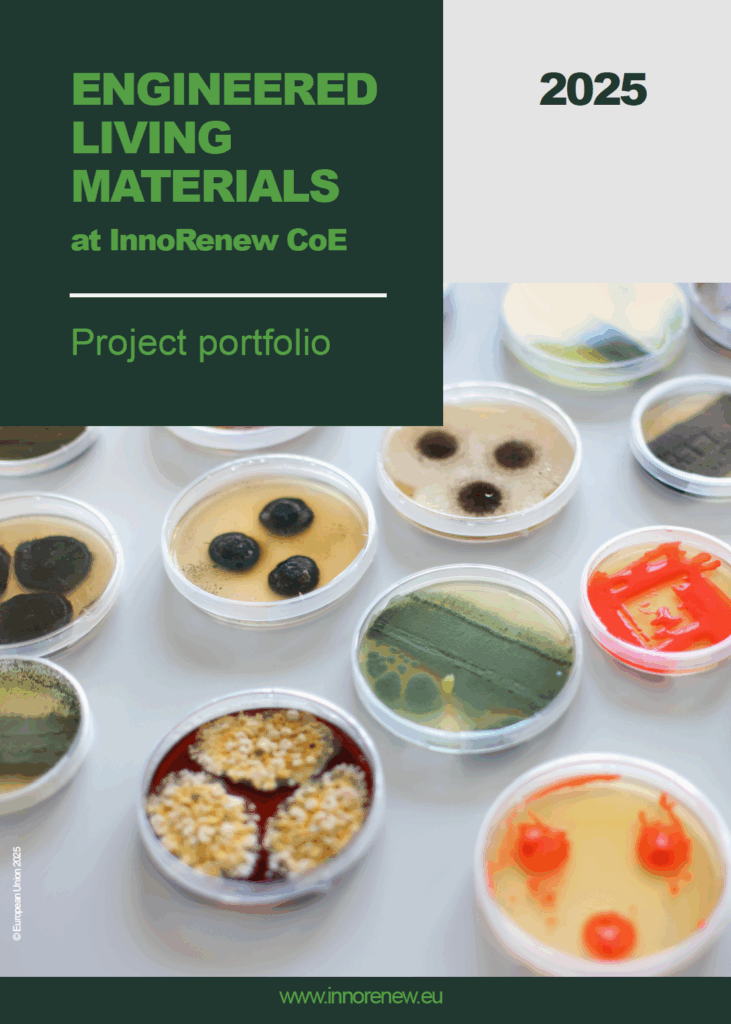

The ARCHI-SKIN project contributes to the rapidly expanding field of Engineered Living Materials (ELMs), pioneering approaches where architecture and biology merge to create adaptive, self-sustaining, and environmentally responsive surfaces. These materials are designed not only to protect buildings but also to sense, react, and evolve together with their surroundings.
Within the broader European research landscape, ARCHI-SKIN builds upon the expertise developed at InnoRenew CoE, where several research initiatives explore living materials as part of a growing ELM research line. Together, these projects investigate how biological systems can inspire new models of regenerative and circular design.
A newly released ELM Research Line brochure presents this collaborative ecosystem, showcasing how InnoRenew’s ELM projects contribute to a shared vision of sustainable innovation – from living coatings and biohybrid composites to adaptive architectural interfaces. The document captures the essence of ELM research: bridging material science, biotechnology, and design culture to shape the future of the built environment.
By integrating biological principles into architectural design, ARCHI-SKIN helps redefine the boundaries between the living and the constructed – turning surfaces into active participants in ecological regeneration.
Download the ELM Research Line brochure here – > https://zenodo.org/records/17106693